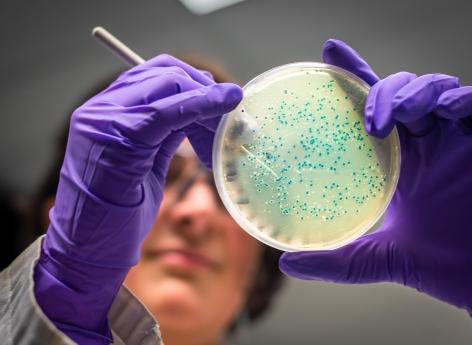

Antibiorésistance
Les nanoplastiques peuvent réduire l'efficacité des antibiotiques
Des scientifiques ont observé les effets des particules nanoplastiques présentes dans l’organisme sur l’efficacité des antibiotiques et le risque d’antibiorésistance.
- Par Joséphine Argence
- Commenting
- Manjurul/IStock
Une utilisation massive et répétée des antibiotiques peut conduire à une résistance des bactéries à ces médicaments. "La résistance bactérienne est devenue un phénomène global et préoccupant (…) Pour éviter le pire, la communauté internationale se mobilise", note l’Institut national de la santé et de la recherche médicale (Inserm).
Les interactions des nanoplastiques sur les antibiotiques
Outre la mauvaise utilisation des antibiotiques, d’autres facteurs pourraient également favoriser l’antibiorésistance. Au cours de récents travaux, publiés dans la revue Scientific Reports, une équipe de recherche internationale s’est notamment intéressée à la manière dont les particules nanoplastiques présentes dans l’organisme peuvent interagir avec les antibiotiques.
Dans le cadre de cette étude, les chercheurs ont analysé les effets du polyéthylène (PE), du polypropylène (PP) et du polystyrène (PS) sur la tétracycline, un antibiotique utilisé pour traiter de nombreuses infections bactériennes. Ces types de plastiques sont notamment présents dans les emballages ou le nylon 6,6, utilisé pour la composition de textiles (vêtements, tapis, rideaux…).
Particules nanoplastiques : un haut risque de résistance aux antibiotiques
À la suite des tests menés avec des modèles informatiques complexes, les scientifiques ont constaté que les particules nanoplastiques peuvent se lier à la tétracycline et altérer ainsi son efficacité. "La liaison était particulièrement forte avec le nylon (…) La charge en micro et nanoplastiques y est environ cinq fois plus élevée qu'à l'extérieur. Le nylon en est l'une des raisons : il est libéré des textiles et pénètre dans le corps par la respiration", a expliqué le Docteur Lukas Kenner, co-auteur de l’étude et chercheur en cancérologie à la Médical University of Vienna (Autriche). Cette liaison entre l’antibiotique et les particules nanoplastiques pourrait donc réduire l’efficacité des antibiotiques.
De plus, les chercheurs ont observé que la liaison aux nanoplastiques pourrait acheminer l’antibiotique vers d’autres sites non désirés de l’organisme, ce qui diminuerait son efficacité et induirait d’autres effets indésirables.
Les particules nanoplastiques qui se lient fortement à la tétracycline pourraient aussi contribuer à la formation de bactéries antibiorésistantes. "À l'heure où la résistance aux antibiotiques devient une menace de plus en plus grande à l'échelle mondiale, de telles interactions doivent être prises en compte", a souligné Lukas Kenner.